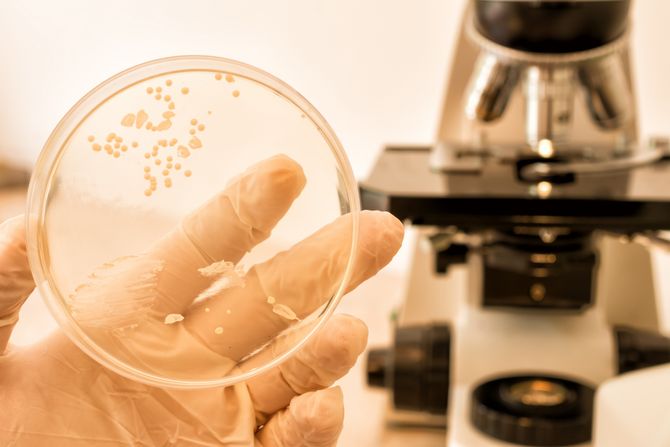
Ilustracija

Otkrivena nova vrsta pijavice: Dobila crnogorsko naučno ime
Na severu u oblasti Komova, naučnici su otkrili novu vrstu pijavice koja je dobila naučno ime po Crnoj Gori - Dina crnogorenzis i jedna je od najređih vrsta u crnogorskoj fauni. Reč je o krupnoj i veoma ugroženoj vrsti, sa izuzetno neobičnim i jedinstvenim životnim ciklusom.
Na šumskim izvorima na planini Komovi naučnici su otkrili žućkastu, pegavu - novu vrstu pijavice kojoj su dali ime po Crnoj Gori- Dina crnogorensis.
"Jedna jedinstvena vrsta koja naseljava područje sjevernog dela Crne Gore, uglavnom izvore, gde živi kao predator i hrani se drugim sitnim organizmima koje može naći u ovom jedinstvenom ekosistemu", rekao je profesor evolucije i biologije na UCG, Vladimir Pešić.
Osim ove, profesor Pešić sa saradnicima otkrio je još dve vrste pijavica - afričku koja živi kao parazit na nilskom konju i vrstu koja ja je prisutna gotovo na celom evropskom kontinentu. Bez obzira na veličinu, svaka vrsta u prirodi ima svoju ulogu.
Profesor Pešić kaže da se svi slažu da će ubudućih 30-40 godina najveći broj bioloških vrsta nestati.
"Mnoge vrste koje će nestati nikad neće biti opisane, a mnoge među tim vrstama će biti vrste koje će nositi i lekove i nosiće mnoge stvari koje su čovečanstvu potrebne", rekao je Pešić.
Zato je neophodno zaštititi staništa na kojima se nalaze retke vrste.
"Štititi staništa u Crnoj Gori je jako teško jer je prostor kategorija za koju postoji oštra konkurencija. Ja se nažalost bojim se da će pijavice izgubiti tu borbu, ne samo pijavice, nego mnoge druge grupe organizama u poređenju sa ekonomskim drugim benefitima koje taj prostor nosi", poručio je profesor Pešić.
Svoj doprinos profesor Pešić će dati tako što će napraviti javnu DNK bazu Crne Gore, što će omogućiti praćenje i očuvanje ugroženih vrsta.
(Telegraf.rs/RTCG)
Video: Deki Miodragu rekli da će uskoro da umre, on je za kraj imao samo jednu želju
Nauka Telegraf zadržava sva prava nad sadržajem. Za preuzimanje sadržaja pogledajte uputstva na stranici Uslovi korišćenja.



Shandor
Milo ! Svaka slicnost je slucajna
Podelite komentar